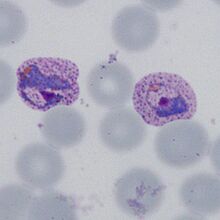
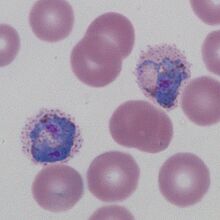

Stained correctly
From haematologyetc.co.uk
Navigation
Go Back
| Why is there an optimal pH for malaria evaluation?
Trophozoites of P.vivax stained at pH7.4 (A) or pH6.9 (B). Note that staining at the more alkaline conditions (pH7.4) gives the red cell a pale blue colour when compared to the acidic conditions (pH6.9), with these conditions making both the trophozoite and the added cytoplasmic dots more visible, although the key features can be seen at either pH. Description
|